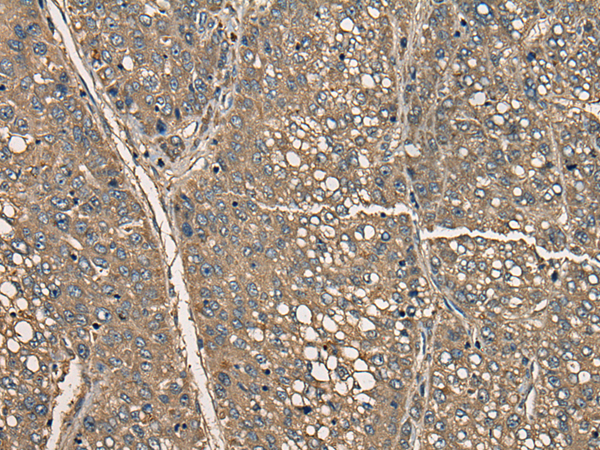
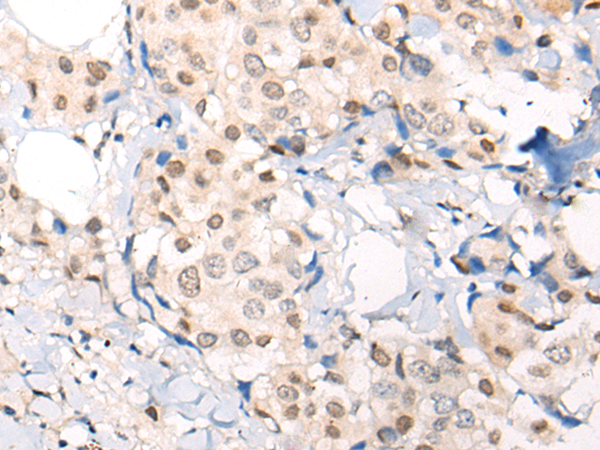
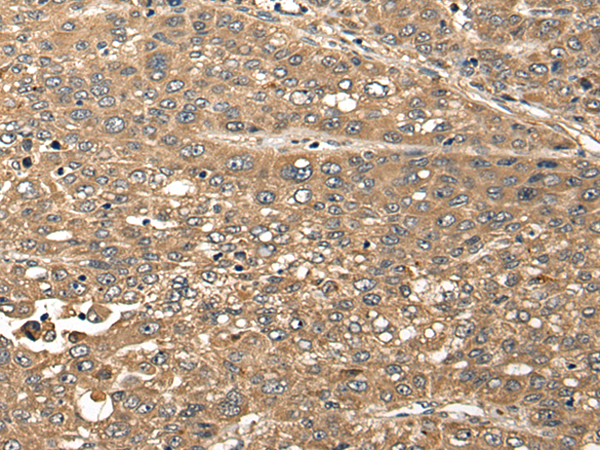

-
分类: 科研抗体货号: P06100别名: C16orf44应用: IHC反应种属: Human, Mouse, Rat
-
分类: 科研抗体货号: P06057别名: EL3; HS2; SPH2; HSPTB1应用: IHC反应种属: Human
-
分类: 科研抗体货号: P06095别名: CAMP; CHAMP; MRD40; ZNF828; C13orf8应用: WB,IHC反应种属: Human, Mouse
-
分类: 科研抗体货号: P06155别名: T1; LEU1应用: IHC反应种属: Human, Mouse, Rat
-
分类: 科研抗体货号: P06130别名: CAMK; CAMKG; CAMK-II应用: WB,IHC反应种属: Human, Mouse, Rat
-
分类: 科研抗体货号: P06141别名:应用: WB,IHC反应种属: Human, Mouse, Rat
-
分类: 科研抗体货号: P06092别名: FFR; ANG2; ANG3; C11orf2; C11orf3应用: IHC反应种属: Human, Mouse
-
分类: 科研抗体货号: P06126别名:应用: WB,IHC反应种属: Human
-
分类: 科研抗体货号: P06091别名: BCA3; C11orf17应用: IHC反应种属: Human, Mouse
-
分类: 科研抗体货号: P06139别名: CIR应用: IHC反应种属: Human

鄂公网安备42018502007531号
鄂公网安备42018502007531号

